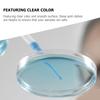
10pcs Petri Dish Plastic With Lid Science Experiment Culture Plate Classroom Laboratory Supplies Sterile Agar Plates Chemistry
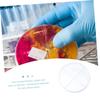
10pcs Cell Culture Dish Petri Dish for Laboratory Cell Culture Petri Dish School Petri Dish Four Compartments Petri Dish Portable Petri Dish Plastic

The website doesn't support your browser. Please update your browser or download a different one
Items found in search "
Petri dish
"Specify category
Best petri dish - 93 products on Joom
You'll find the best petri dish at great prices on Joom — from 2 to 79 USD. A wide range of available colours in our catalogue: White. Only high-quality materials: Aluminium, Rubber, Stone, Iron, Twill; and popular brands: AS ONE, HOLBEIN.
New reviews about petri dish
Popular categories
- shrimp feeding dish
- dish washing sponge
- dish cleaner
- dishes set
- dish drying mat
- dish sponge holder
- wooden soap dish
- kitchen dish drainer
- dish rack
- soap dish
- dish washing brush
- bathroom soap dish
- shower soap dish
- serving dishes
- cat dish
- dish brush
- dish sponges
- dish drainer rack
- dish drainer
- dish wand
- dish cloth holder
- pizza dishes
- microwave dishes
- satellite dish
- corelle dishes
- dishes sets
- dishes
- butter dish
- ceramic butter dish
- butter dish with lid
- solid dish soap
- dish soap
- dish hopper
- melamine dishes
- dish cloth
- dish organizer
- dish cabinet
- dish towels
- dish storage
- swedish dish cloths
- cabinet dish rack
- stoneware dishes
- dog dishes
- chafing dishes
- ring dish
- pyrex dishes
- dish detergent
- 2 quart baking dish
- trinket dish